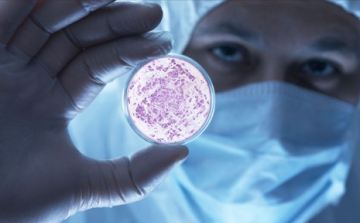
Őssejttel gyógyítanák az 1-es típusú cukorbetegséget

Hírek

2014. Október 15. 10:41, szerda |
Milyen házikedvencet vegyünk?
Bizonyára megvan a saját kedvence mindenkinek. Egy aranyos kiscica, egy játékos kiskutya, egy furfangos papagáj vagy egyéb csodabogár.

2014. Október 15. 08:00, szerda |
Szakíts, ha bírsz! 6+1 tipp, mit tegyünk szakítás után
Pocsék dolog, ha az ember lányát álmai lovagja egyik pillanatról a másikra dobja. Mégis, számtalanszor megtörténik ez velünk, és mi nem tehetünk mást, mint hogy erősek maradunk, és túléljük a dolgot.

2014. Október 15. 08:00, szerda |
Kellemetlen randi-bakik – Hogyan kezeljük?
Az ismerkedés alatt rengeteg kellemetlen szituáció adódhat számunkra, különösen, ha például az interneten ismerkedünk. Néhány tipp, hogyan kezeljük a különböző kínos helyzeteket!

2014. Október 15. 05:00, szerda |
Világhálóról vadászik az adóhivatal

2014. Október 15. 05:00, szerda |
Nem szeretünk csapatban dolgozni

2014. Október 15. 05:00, szerda |
Közdefibrillátort helyeztek el a fővárosban

2014. Október 15. 05:00, szerda |
Mi áll a gyerekkori cukorbetegség hátterében?

2014. Október 15. 05:00, szerda |
Herzog-kincsek a Magyar Nemzeti Múzeumban

2014. Október 15. 05:00, szerda |
Kivonulhatnak a webboltok a reklámadó miatt
2014. Október 15. 05:00, szerda |
Őssejttel gyógyítanák az 1-es típusú cukorbetegséget

2014. Október 15. 05:00, szerda |
Több kárt okozhat a dohányzás, mint eddig gondolták

2014. Október 15. 05:00, szerda |
Magyarországon is kimutatták a kéknyelv-betegséget
